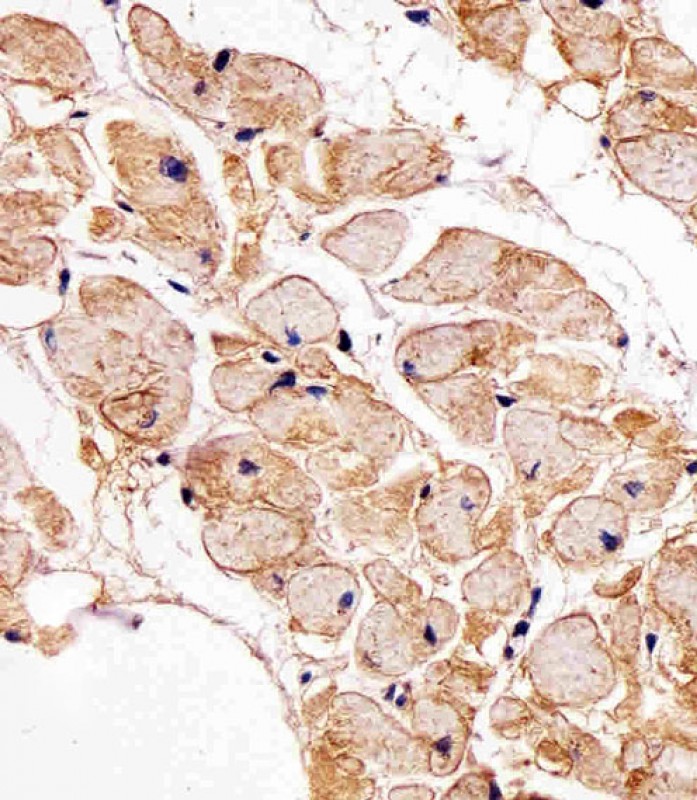

-
分类: 科研抗体货号: P32526别名: NADH dehydrogenase [ubiquinone] iron-sulfur protein 7, mitochondrial, Complex I-20kD, CI-20kD, NADH-ubiquinone oxidoreductase 20 kDa subunit, PSST subunit, NDUFS7应用: WB反应种属: Human, Mouse
-
分类: 科研抗体货号: P32511别名: Probable G-protein coupled receptor 150, GPR150应用: WB反应种属: Human
-
分类: 科研抗体货号: P32520别名: CCAAT/enhancer-binding protein delta, C/EBP delta, Transcription factor CELF, Cebpd, Celf应用: WB反应种属: Human, Mouse, Rat
-
分类: 科研抗体货号: P32524别名: Sarcospan, K-ras oncogene-associated protein, Kirsten-ras-associated protein, SSPN, KRAG应用: WB,IHC反应种属: Human
-
分类: 科研抗体货号: P32508别名: Small ubiquitin-related modifier 2, SUMO-2, HSMT3, SMT3 homolog 2 {ECO:0000312|HGNC:HGNC:11125}, SUMO-3, Sentrin-2, Ubiquitin-like protein SMT3B, Smt3B, SUMO2 (<a href="http://www.genenames.org/cgi-bin/gene_symbol_report?hgnc_id=11125" target="_blank">HGN应用: WB,IF反应种属: Human, Rat
-
分类: 科研抗体货号: P32519别名: Cell growth regulator with EF hand domain protein 1, Cell growth regulatory gene 11 protein, Hydrophobestin, Cgref1, Cgr11应用: WB反应种属: Rat
-
分类: 科研抗体货号: P32523别名: Plakophilin-4, p0071, PKP4应用: WB,IHC反应种属: Human, Mouse
-
分类: 科研抗体货号: P32533别名: Calcium-binding mitochondrial carrier protein SCaMC-2, Mitochondrial ATP-Mg/Pi carrier protein 3, Mitochondrial Ca(2+)-dependent solute carrier protein 3, Small calcium-binding mitochondrial carrier protein 2, Solute carrier family 25 member 25, SLC25A25,应用: WB,IHC反应种属: Human, Mouse, Rat
-
分类: 科研抗体货号: P32518别名: COBW domain-containing protein 1, Cobalamin synthase W domain-containing protein 1, Cbwd1应用: WB反应种属: Mouse, Rat
-
分类: 科研抗体货号: P32522别名: Enhancer of polycomb homolog 1, EPC1应用: WB反应种属: Human, Mouse

鄂公网安备42018502007531号
鄂公网安备42018502007531号

